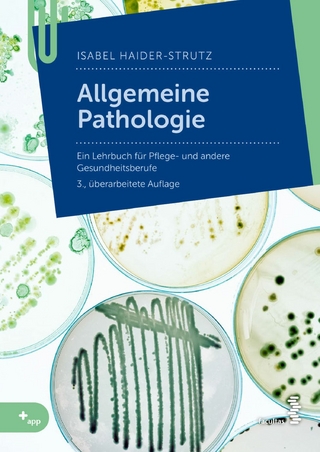
Allgemeine Pathologie

eBook Download (PDF)
2020
|
Auflage:
1
|
GRIN Verlag
ISBN: 9783346236968
13,99 €
(CHF 13,65) (inkl. MwSt)
(CHF 13,65) (inkl. MwSt)
- Download sofort lieferbar